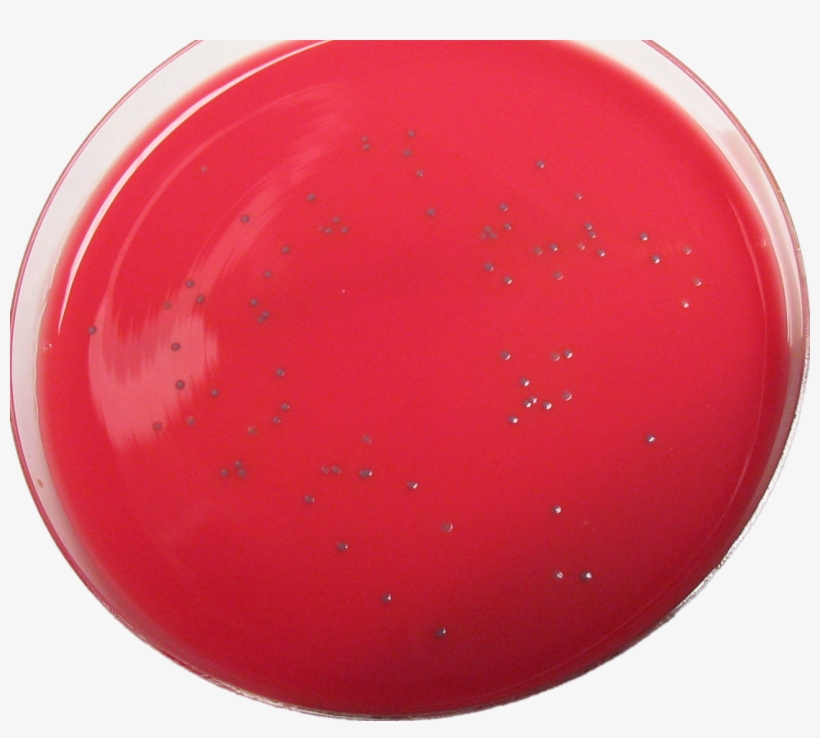
Smooth L'mono-trans - Listeria Monocytogenes On Dra Agar, transparent png download

Smooth L'mono-trans - Listeria Monocytogenes On Dra Agar is a high-resolution transparent PNG image. It is a very clean transparent background image and its resolution is 1288x1097 , please mark the image source when quoting it. Smooth L'mono-trans - Listeria Monocytogenes On Dra Agar is a completely free picture material, which can be downloaded and shared unlimitedly. Seeking more PNG image null? Please to search on SeekPNG.com.
| Image type | PNG |
|---|---|
| Resolution | 1288x1097 |
| Name | Smooth L'mono-trans - Listeria Monocytogenes On Dra Agar |
| License | Personal Use |
| Size | 2008 KB |
| Views | 15 |
| Downloads | 2 |